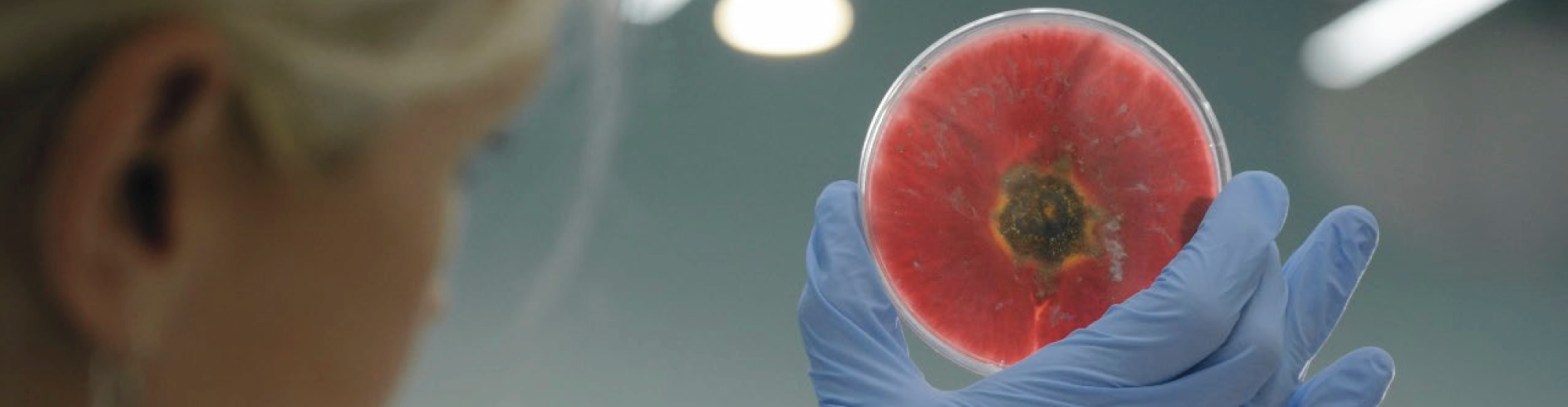

My name is Anne Madden, and I’m glad I got bed bugs. But before you write me off as a masochistic idiot with a flair for the dramatic, let me back up. I have been afraid of small bugs since as far back as I can remember. I am not, however, generally afraid of bugs.Continue reading “How getting bed bugs made me a better scientist”
Tag Archives: Science
A last gasp of hope for science: How to make science research relevant in the age of Trump.
A proposal of how to make science research relevant in the age of Trump.